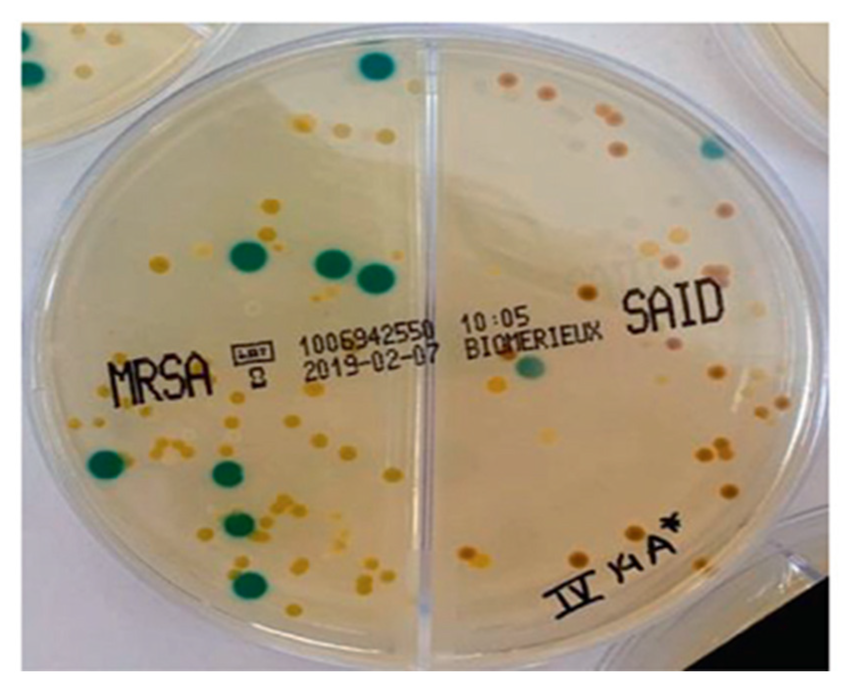

ChromID MRSA is a specialized chromogenic agar medium produced by bioMérieux for the rapid screening and direct identification of methicillin-resistant Staphylococcus aureus (MRSA) in clinical specimens.
Key Characteristics and Function
- Selectivity: It incorporates an antibiotic mixture, primarily cefoxitin, which inhibits the growth of most other bacteria and yeasts, as well as methicillin-sensitive S. aureus (MSSA).
- Incubation Time: Results are typically readable after 18 to 24 hours of aerobic incubation at 35–37°C. While a positive green result can often be seen at 18 hours, negative plates should be held for a full 24 hours.
Usage and Application
- Clinical Screening: It is primarily used for active surveillance of MRSA carriers through nasal, throat, or wound swabs to prevent nosocomial (hospital-acquired) infections.
- Interpretation: Any green colony is considered a positive result for MRSA. Other species in the Staphylococcus genus that may grow are usually inhibited or appear as colorless/beige colonies.
- Variants:
- chromID MRSA SMART: An optimized version designed for even higher sensitivity and lower limits of detection.
- chromID MRSA/S. aureus: A bi-plate that allows for the simultaneous screening of MRSA on one side and the general isolation of S. aureus on the other.
For official technical specifications and safety data, you can refer to the bioMérieux product catalog.
Estimated 2026 Pricing
Current market data for 2026 indicates the following approximate costs for prepared plated media:
- chromID MRSA (20 plates): Typically ranges from $230 to $300 USD per kit.
- Cost per Plate: Approximately $11.50 to $15.00 USD per 90mm plate.
- chromID MRSA/S. aureus Bi-Plate: These specialized plates (which detect both MRSA and general S. aureus) generally command a higher premium per unit compared to the mono-plate format.
Leave a Reply